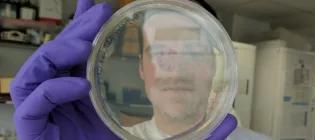
Member of Chris French Lab holding a petri dish

Welcome to the Chris French Laboratory
Funding agencies

Biotechnology and Biological Sciences Research Council (BBSRC)

EastBio (East of Scotland Bioscience Doctoral Training Partnership)

Petroleum Technology Development Fund (PTDF)

Engineering and Physical Sciences Research Council (EPSRC)

Industrial Biotechnology Innovation Centre (IBioIC)

Comisión Nacional De Investigación Científica Y Tecnológica (Conicyt)

The Microbiology Society

SynthSys - Centre for Synthetic and Systems Biology

SynbiCITE: Synthetic Biology Accelerator

Islamic Development Bank (IsDB)
Lab location
Roger Land Building
The King's Buildings, University of Edinburgh
Edinburgh, EH9 3JQ
This article was published on